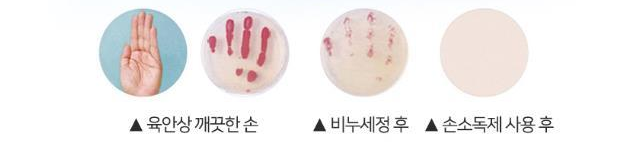

최근 코로나19로 인해 마스크, 손소독제를 비롯, 위생용품들에 대한 관심이 그 어느 때보다 높아졌습니다.
마스크의 경우 KF94, KF80 등 제품 등급에 대해 많은 이들이 이미 잘 알고 있지만 손소독제와 손세정제의 차이는 잘 모르고 있는 분들이 많습니다.
손소독제와 손세정제의 차이는 무엇일까요?
손소독제는 의약외품, 손세정제는 화장품입니다.
아래는 식품의약품안전처 공식블로그에서 게시한 이미지로 손소독제와 손세정제의 차이를 쉽게 확인할 수 있습니다.

손소독제와 손세정제는 사용 목적과 용도가 다른 제품입니다.
코로나19 이슈로 인해 값싼 원재료를 가지고 급하게 손세정제를 제조해 판매하는 업체들이 굉장히 많아진 상태입니다.
하지만 의약외품이 아닌 화장품으로 '손세정제'를 내걸고 판매하고 있는 제품들이 많고 심지어 손소독제로 홍보를 하며 판매 중인 제품이 허다합니다.
에탄올 함량으로 손소독제와 손세정제를 구분하는 것이 아닙니다.
의약외품인지 아닌지, 식약처 인증 허가증, 시험성적서는 보유하고 있는 제품인지 꼭 확인해야 소비자의 피해를 줄일 수 있을 것입니다.
우후죽순으로 늘어나고 있는 가짜 손소독제, 제대로 된 제품을 찾아 구매해야 합니다.
식약처 인증 허가증과 KTR 시험성적서를 보유하고 살균소독제 '순수케어'로 높은 신뢰도를 보여주고 있는 (주)비츄인의 휴대용 손소독제는 코로나19 이슈 이전부터 시장에서 쭈욱 인정받고 있는 제품입니다.



출퇴근을 비롯한 일상 생활에서 휴대하며 사용하기 쉽도록 새롭게 출시한 휴대용 손소독제는 큰 관심을 얻고 있습니다.
*** 에탄올 70% 60ml 펌프식 휴대용 손소독제(추천)
비츄인 핸즈앤퓨어 60ml 에탄올 70% : 운도도씨
비츄인 핸즈앤퓨어 60ml 에탄올 70%
smartstore.naver.com
휴대용 60ml 손소독제 제품은 펌프타입으로 주머니에 넣어도 부피감이 적어 휴대가 용이합니다.
또한 마개가 있어 위생적인 보관과 간편한 사용이 가능하며 공기 중 노출로 인한 오염 우려도 없습니다.
휴대용 손소독제 60ml 5개 세트 손세정제 겔타입 새니타이저 비츄인 : 운도도씨
휴대용 손소독제 60ml 5개 세트 손세정제 겔타입 새니타이저 비츄인
smartstore.naver.com
바이러스 감염증을 예방하기 위한 휴대용 손소독제는 보다 까다로운 선택이 필요합니다.
제품 홍보를 위한 과도한 에탄올 함량 제품은 오히려 피부 건조증을 유발해 세균 증식 환경을 조성할 수 있으며 화장품으로 분류되는 손세정제는 그 신뢰성을 담보하기 어려울 수 있습니다.
오랫동안 꾸준히 기업을 영위해 온 믿을만한 회사의 신뢰할 수 있는 제품을 선택해야 할 때입니다.
기회가 왔다고 우후죽순 뛰어들어 들어보지도 못한 브랜드의 저가 제품을 구입할 것이냐, 한 우물을 파 시장에서 꾸준히 인정받아온 브랜드의 인증받은 제품을 구매할 것이냐.
선택은 시장이 하며, 모든 소비자들은 현명합니다.
'운도도씨 뉴스' 카테고리의 다른 글
| 손소독만큼 중요한 휴대폰 위생, 스마트폰 살균 소독제로 관리 (3) | 2020.05.19 |
|---|---|
| 뱃살 고민, 건강하고 효과적인 다이어트 보조제 추천 (1) | 2020.05.18 |
| 식당(음식점) 손님들을 위한 일회용 손소독제 추천 (0) | 2020.05.18 |
| 트리에탄올아민 카보머, 손소독제 성분 안전성 (0) | 2020.04.02 |
| 독감, 코로나 바이러스, 중국 우한 폐렴 | 휴대용 손세정제, 손소독제 (0) | 2020.01.25 |
| 아이와 함께 하는 양털 후리스 방울 목도리 (3) | 2019.12.02 |
| 가성비 최고 승무원 압박스타킹 (0) | 2019.11.20 |
| 가수 요요미 리프팅밴드(라라밴드) 영상 및 후기 (0) | 2019.11.19 |